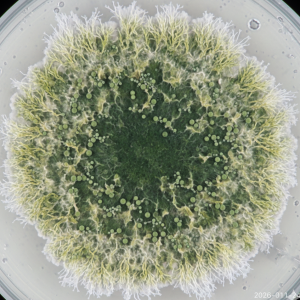

Sarmila Bidari Acharya)
MSc.(Ag) Agronomy
Trichoderma is a beneficial micro-organism that can be found naturally in soil. It is a good fungus for agriculture that lives near the roots of plants and keeps harmful germs away. It is a natural medicine for soil and plants helping them grow better and healthy.
Beyond disease control, it also acts as a biological shield against climate stress in agriculture. In the face of shifting climate patterns, Trichoderma- a genus of soil-dwelling fungi has moved from being a simple plant protector to a vital tool for climate-resilient agriculture. These fungi enhance a plant’s ability to survive heat, drought, and high salinity.
Stress Tolerance Mechanism
Through colonization, Trichoderma forms a symbiotic relationship with plant roots. Once it gets established in roots, it triggers in physiological changes:
• ROS Scavenging: Climate stress like extreme heat causes plants to produce Reactive Oxygen Species (ROS) that damage cells. Trichoderma helps in boosting the production of antioxidant enzymes like Superoxide Dismutase (SOD) and peroxidase, these help in reducing cellular damage.
• Osmotic Adjustment: In drought conditions, Trichoderma helps plant accumulate osmoprotectants that prevent the plant from wilting by maintaining cell turgor.
• Root System: Trichoderma secretes auxins (growth hormones) that encourage the development of deep, lateral roots, allowing the plant to tap into deeper water reserves during dry spells.

How Trichoderma helps to cope with various Stress Factors
• Drought: Trichoderma enhances water-use efficiency and closes stomata faster to prevent transpiration loss.
• Salinity: Regulates ion transporters to prevent toxic levels of sodium from entering the plant while maintaining potassium levels.
• Extreme Heat: Induces Heat Shock Proteins that protect cellular proteins from denaturing.
• Flooding: Trichoderma mitigates the oxidative burst and helps plants recover faster from anaerobic soil conditions.
The Double Benefit of Trichoderma
Climate change often leads to the migration of new pests and diseases. Trichoderma provides a secondary layer of defense:
Induced Systemic Resistance: It improves the plant’s immune system, making it faster and stronger at responding to pathogens that thrive in warmer climates.
Nutrient Solubilization: Trichoderma breaks down locked-up phosphorus and micronutrients in the soil, making the plant nourished even when the soil environment becomes harsh.
Implementation of Trichoderma:
To get the full advantage of Trichoderma in a changing climate:
Seed Treatment: Coating seeds ensures better germination and protects seedlings from early diseases.
Soil Enrichment: Mixing Trichoderma with organic compost provides nutrients to establish itself in degraded soil and helps in controlling soil borne diseases.
Strain Selection: Species like Trichoderma harzianum vs. T. asperellum perform better in different temperatures.
Trichoderma for Rice and Wheat
Both rice and wheat are highly sensitive to climate shifts: rice to salinity and flooding, and wheat to rising temperatures and drought.
Trichoderma for Rice (Oryza sativa)
Rice is usually grown in waterlogged or high-salinity areas. The primary challenge is maintaining growth when soil oxygen is low or salt levels are high.
The Salinity Solution: In saline-alkali soil, Trichoderma helps rice plants maintain a healthy Potassium/Sodium ratio. It limits the uptake of toxic sodium and increases the concentration of potassium, which is vital for grain filling.
Submergence Recovery: If a paddy is flash-flooded, Trichoderma helps the plant recover faster by suppressing the rapid growth of water-borne pathogens.
Application: Seed priming or soaking seeds in a Trichoderma suspension is highly effective.
Trichoderma for Wheat (Triticum aestivum)
Wheat faces its greatest climate threats during the terminal heat stage (grain filling) and during prolonged dry spells.
Key Strains: T. asperellum and T. hamatum are often more heat-tolerant.
Heat Stress Mitigation: Heat causes wheat to mature early, leading to shriveled grains. Trichoderma induces the production of antioxidants that protect the photosynthetic machinery in the leaves, allowing the plant to continue producing energy even at 30-35 degree centigrade.
Drought Resilience: Trichoderma promotes the synthesis of Abscisic acid (ABA) in wheat, which signals the plant to close its stomata more efficiently, reducing water loss through transpiration by up to 15-20%.
Application: Soil drenching or mixing of Trichoderma with bio-char at the time of sowing is preferred to ensure the fungi settle deep into the rhizosphere where wheat roots develop.
Trichoderma is more than just a fungicide; it is a multifunctional biological catalyst that helps plants navigate the unpredictable extremes of modern climate change. As synthetic chemicals become less effective in volatile weather, biological like Trichoderma are becoming the backbone of Climate-Smart Agriculture.









